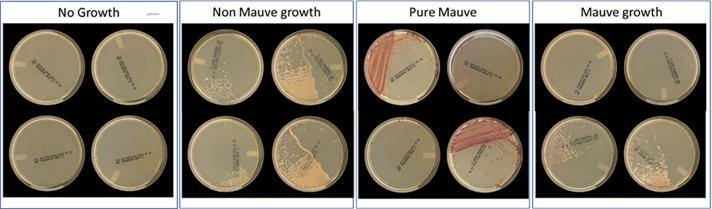
https://cdn.ncbi.nlm.nih.gov/pmc/blobs/3a4b/11077980/bf97468323ab/jcm.01445-23.f001.jpg

BD Kiestra Total Lab 自动化系统上的 MRSA CHROM 成像应用程序对耐甲氧西林金黄色葡萄球菌的自动化检测。
Automated detection of methicillin-resistant with the MRSA CHROM imaging application on BD Kiestra Total Lab Automation System.
机构信息
Northshore University Health System, Evanston, Illinois, USA.
Becton, Dickinson and Company- Integrated Diagnostic Solutions, Sparks, Maryland, USA.
出版信息
J Clin Microbiol. 2024 May 8;62(5):e0144523. doi: 10.1128/jcm.01445-23. Epub 2024 Apr 1.
The virulence of methicillin-resistant (MRSA) and its potentially fatal outcome necessitate rapid and accurate detection of patients colonized with MRSA in healthcare settings. Using the BD Kiestra Total Lab Automation (TLA) System in conjunction with the MRSA Application (MRSA App), an imaging application that uses artificial intelligence to interpret colorimetric information (mauve-colored colonies) indicative of MRSA pathogen presence on CHROMagar chromogenic media, anterior nares specimens from three sites were evaluated for the presence of mauve-colored colonies. Results obtained with the MRSA App were compared to manual reading of agar plate images by proficient laboratory technologists. Of 1,593 specimens evaluated, 1,545 (96.98%) were concordant between MRSA App and laboratory technologist reading for the detection of MRSA growth [sensitivity 98.15% (95% CI, 96.03, 99.32) and specificity 96.69% (95% CI, 95.55, 97.60)]. This multi-site study is the first evaluation of the MRSA App in conjunction with the BD Kiestra TLA System. Using the MRSA App, our results showed 98.15% sensitivity and 96.69% specificity for the detection of MRSA from anterior nares specimens. The MRSA App, used in conjunction with laboratory automation, provides an opportunity to improve laboratory efficiency by reducing laboratory technologists' labor associated with the review and interpretation of cultures.
耐甲氧西林金黄色葡萄球菌(MRSA)的毒力及其潜在致命后果,需要在医疗保健环境中快速准确地检测出 MRSA 定植患者。本研究使用 BD Kiestra 全自动实验室检测系统(TLA)和 MRSA 应用软件(MRSA App),该应用软件利用人工智能技术来解读显色培养基(CHROMagar 显色培养基)上的颜色信息(紫色菌落),以指示 MRSA 病原体的存在,对来自三个部位的鼻前庭标本进行紫色菌落的检测。将 MRSA App 的检测结果与熟练的实验室技师对琼脂平板图像的人工判读进行比较。在评估的 1593 个标本中,MRSA App 与实验室技师判读对 MRSA 生长的检测结果有 1545 个(96.98%)是一致的[敏感性 98.15%(95%置信区间,96.03,99.32)和特异性 96.69%(95%置信区间,95.55,97.60)]。这是首次对 BD Kiestra TLA 系统联合 MRSA App 的多中心评估。使用 MRSA App,我们的研究结果显示,该应用对鼻前庭标本检测 MRSA 的敏感性为 98.15%,特异性为 96.69%。MRSA App 与实验室自动化相结合,为减少实验室技师在阅读和解释培养物方面的劳动量,从而提高实验室效率提供了机会。